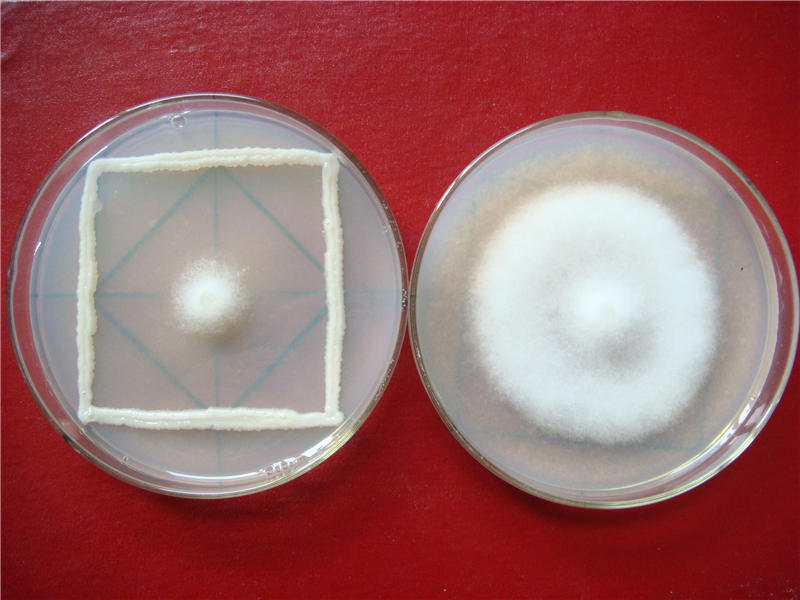
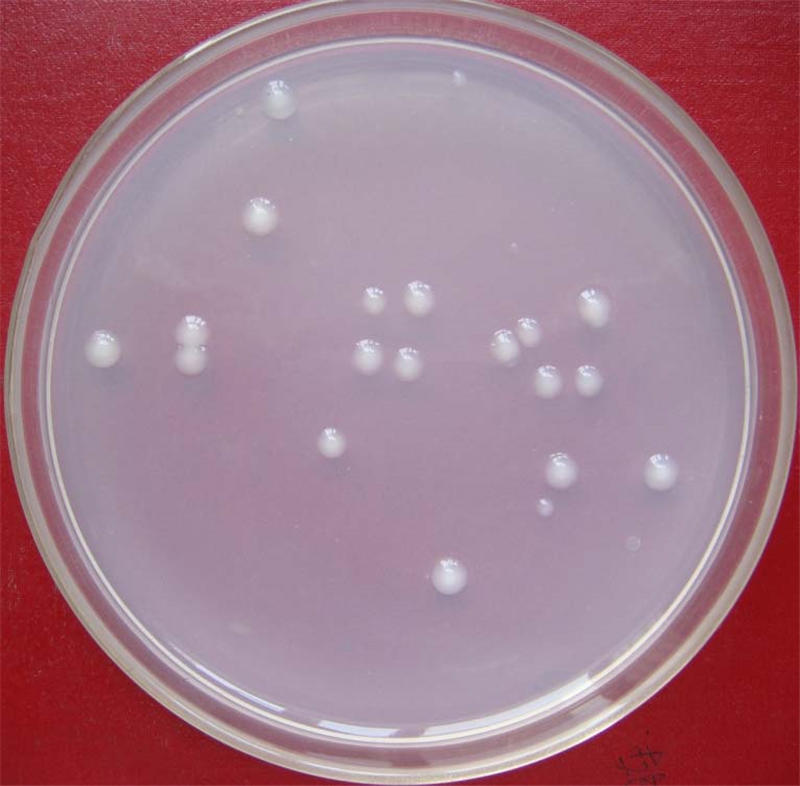

马铃薯专用高效生物钾肥MK4和防病型当归专用生物有机肥料DZF-363由内部绝密信封料39土壤肥料与节水农业研究所研制。
MK4可在马铃薯需钾高峰期同步释放钾元素,对马铃薯晚疫病防治效果显著。在甘肃省中部干旱区、高寒阴湿区和河西走廊马铃薯大田生产中,增产11%~15.4%,淀粉含量提高3.3%~7.5%。
DZF-363能显著增加当归根际土壤细菌多样性,改变细菌群落结构,提高根际土壤脲酶和磷酸酶活性,减轻当归根腐病,显著提高当归产量。在大田试验示范中,增产15.6%~18.8%,根腐病防效52.0%。